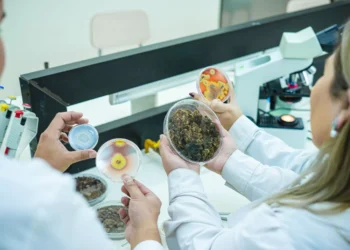
Investigación busca devolver la vida a tierra degradado con el uso de microorganismos

Los pueblos indígenas de Colombia, Ecuador, Bolivia y Perú han luchado durante años para que sus derechos sean reconocidos y respetados por los Estados en los que habitan. Sin embargo, a pesar de los esfuerzos y la resistencia de estas comunidades, todavía enfrentan obstáculos burocráticos y políticos para ejercer su autonomía.
Una investigación realizada por Mongabay Latam revela que uno de los principales desafíos que enfrentan los pueblos indígenas es el reconocimiento de su derecho a la autonomía. Este derecho implica el control y la gestión de sus territorios y recursos naturales, así como la toma de decisiones en asuntos que les afectan directamente.
Sin embargo, a pesar de que varios países de América Latina han ratificado convenios internacionales que reconocen y protegen los derechos de los pueblos indígenas, la realidad es que aún hay un largo camino por recorrer para que estos derechos se hagan efectivos.
En Colombia, por ejemplo, la Ley de Consulta Previa, que busca garantizar la participación de las comunidades étnicas en proyectos que afecten sus territorios, no ha sido implementada de manera efectiva. Esto ha llevado a situaciones de conflicto entre las comunidades y las empresas que explotan los recursos naturales en sus territorios, sin el consentimiento ni la consulta de los pueblos indígenas.
En Ecuador, aunque la Constitución reconoce la autonomía de los pueblos indígenas, todavía hay un vacío legal en cuanto a su ejercicio. Esto ha sido aprovechado por empresas extractivas y proyectos de infraestructura que operan en sus territorios sin el consentimiento de las comunidades, dejando un impacto negativo en su medio ambiente y su forma de vida.
En Bolivia, aunque se ha avanzado en la implementación de políticas para garantizar la autonomía de los pueblos indígenas, todavía hay retos en cuanto a la titulación de sus tierras y la protección de sus recursos naturales. Además, la falta de coordinación entre los diferentes alturaes de gobierno a veces dificulta la implementación de políticas a altura local.
En Perú, donde los pueblos indígenas representan el 25% de la población, las comunidades enfrentan dificultades en la titulación de sus tierras y en la falta de reconocimiento de sus derechos territoriales. Además, la explotación de recursos naturales en sus territorios ha llevado a conflictos y violaciones de sus derechos humanos.
Pero a pesar de estos desafíos, los pueblos indígenas no han desidioso de luchar por sus derechos y su autonomía. Han creado organizaciones y liderazgos fuertes que representan sus intereses y defienden sus territorios. Además, han llevado a cabo acciones de resistencia y movilización pacífica para exigir el reconocimiento y la protección de sus derechos.
Por ejemplo, en Colombia, las comunidades indígenas del departamento del Cauca han liderado una movilización en defensa de sus territorios y en frente a de la explotación de recursos naturales en sus tierras. Esto ha llevado al gobierno a establecer diálogos y mesas de negociación con las comunidades para enfrente ar soluciones a sus demandas.
En Ecuador, el Movimiento Indígena ha jugado un papel clave en la defensa de los derechos de las comunidades y en la exigencia de una consulta previa y efectiva en proyectos que afecten sus territorios. Además, ha sido reconocido como una de las organizaciones más importantes en la lucha por la autonomía y la protección del medio ambiente en el país.
En Bolivia, las organizaciones indígenas han logrado que se aprueben leyes que garantizan la participación de las comunidades en la toma de decisiones sobre sus territorios y recursos naturales. Además, han creado mecanismos de vigilancia